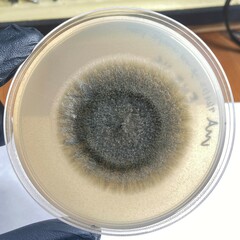
Curvularia
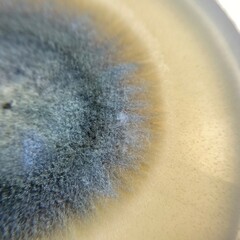
Curvularia
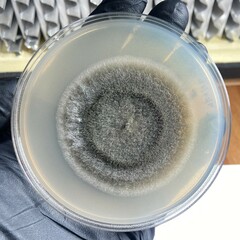
Curvularia
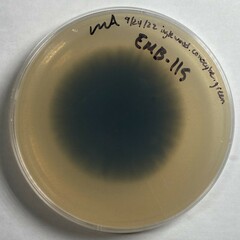
Curvularia
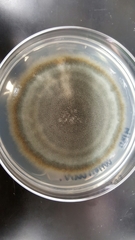
Curvularia
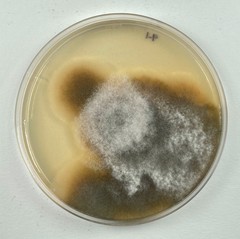
Curvularia
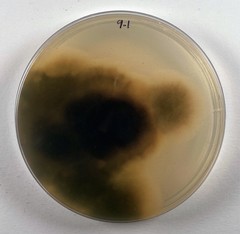
Curvularia
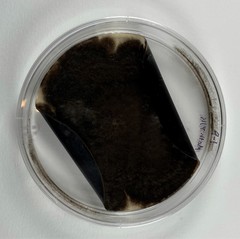
Curvularia
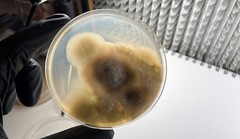
Curvularia

Curvularia: taxon details and analytics
- Domain
- Kingdom
- Fungi
- Phylum
- Ascomycota
- Class
- Dothideomycetes
- Order
- Pleosporales
- Family
- Pleosporaceae
- Genus
- Curvularia
- Species
- Scientific Name
- Curvularia
Summary description from Wikipedia:
Curvularia
Curvularia is a genus of hyphomycete (mold) fungi which can be pathogens but also act as beneficial partners of many plant species. They are common in soil. Most Curvularia species are found in tropical regions, though a few are found in temperate zones.
Curvularia is defined by the type species C. lunata (Wakker) Boedijn.
Curvularia lunata appears as shiny velvety-black, fluffy growth (on the fungus colony surface). These fluffy 'hairs', which really are branching, fine filamentous structures called hyphae, are divided inside by cell walls named septae (-> the hyphae are 'septate'). The walls of these hyphae contain dark pigments, which makes for their black appearance and which is called 'dematiaceous'. The hyphae produce brown spore bearing organs, 'conidiophores', which are distinguished by their 'geniculate' [1] shape, meaning they have bends of abrupt kneelike angles. The immobile, asexual fungal spores born on those conidiophores, the proconidia, have a slightly to distinctly curved shape; they are divided inside by horizontally spreading cell walls (= are 'transversely[2] septate'), and have one expanded cell (the third[clarification needed] cell) at one end (the pore[clarification needed] end of the conidium).
Curvularia can be distinguished from the species Bipolaris and Drechslera by the way (angle) walls (septae) divide the inner structure of their spores.
The name of the teleomorphic state of the type species Curvularia lunata is Cochliobolus lunatus (Fam. Pleosporaceae, Ord. Pleosporales, Cla. Loculoascomycetes, Phy. Ascomycota).
...Images from inaturalist.org observations:
We recommend you sign up for this excellent, free service.
Parent Taxon
Sibling Taxa
Child Taxa
- Curvularia brachyspora
- Curvularia buchloes
- Curvularia cactivora
- Curvularia clavata
- Curvularia cymbopogonis
- Curvularia ellisii
- Curvularia eragrostidis
- Curvularia fraserae
- Curvularia geniculata
- Curvularia gladioli
- Curvularia hawaiiensis
- Curvularia inaequalis
- Curvularia intermedia
- Curvularia lunata
- Curvularia millisiae
- Curvularia neoindica
- Curvularia pallescens
- Curvularia penniseti
- Curvularia portulacae
- Curvularia protuberata
- Curvularia ravenelii
- Curvularia senegalensis
- Curvularia sorghicola
- Curvularia spicifera
- Curvularia trifolii
- Curvularia tsudae
- Curvularia tuberculata
- Curvularia verruculosa